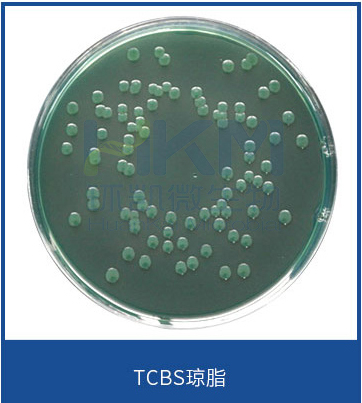
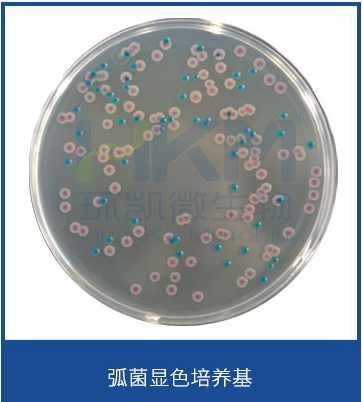

食品微生物检验副溶血性弧菌检验常用培养基原理解析
发布时间:2020-11-26 浏览次数:11597
•蛋白胨提供碳源、氮源、维生素、生长因子;高含量氯化钠和高pH值可以抑制非弧菌类细菌生长,不影响副溶血性弧菌生长。
硫代硫酸盐-柠檬酸盐-胆盐-蔗糖(TCBS)琼脂
•配方中多价蛋白胨、酵母膏粉提供碳氮源、维生素和生长因子;氯化钠可刺激弧菌的生长;蔗糖是可发酵的糖类;胆酸钠、牛胆汁粉、硫代硫酸钠和柠檬酸钠及较高的pH可抑制革兰氏阳性菌和大肠菌群;硫代硫酸钠与柠檬酸铁反应作为检测硫化氢产生的指示剂;溴麝香草酚蓝和麝香草酚蓝是pH指示剂;琼脂是培养基的凝固剂 。
•副溶血性弧菌不发酵蔗糖,不会使培养基pH降低,因而在该培养基上为绿色菌落,创伤和拟态弧菌都不发酵蔗糖,需进一步确证鉴定,霍乱弧菌发酵蔗糖为黄色。
副溶血性弧菌为绿色菌落
•配方中蛋白胨和酵母膏粉提供氮源、维生素、氨基酸和碳源;蔗糖为可发酵的糖类;抑菌剂抑制大部分非弧菌细菌,氯化钠可维持均衡的渗透压;琼脂是培养基的凝固剂;混合色素与副溶血性弧菌、霍乱弧菌和创伤弧菌所对应的酶发生特异性反应,水解底物,释放出显色基团,在淡黄色平板上产生品红色菌落(副溶血性弧菌)和绿-蓝绿色的菌落(霍乱弧菌和创伤弧菌)。
副溶血性弧菌为品(紫)红色菌落
3%氯化钠胰蛋白胨大豆琼脂
•胰蛋白胨、大豆蛋白胨提供氮源、维生素、生长因子;高含量氯化钠可以抑制非弧菌类细菌生长,不影响副溶血性弧菌生长;琼脂为凝固剂。
氧化酶试验
Ø 原理:氧化酶使细胞色素C氧化,氧化型细胞色素C再氧化对苯二胺试剂形成紫色复合物,产生颜色反应。
操作:滴加1滴氧化酶试剂到一小块洁净滤纸上,用玻棒或接种环(铂或塑料)挑取适量新鲜菌苔涂在试剂润湿的纸片上;30秒内出现蓝紫色为阳性,延迟反应或无颜色变化为阴性。

•蛋白胨、牛肉膏粉提供氮源、维生素、矿物质;乳糖、葡萄糖、蔗糖为可发酵糖类,其产酸时通过酚红指示剂测出,酸性呈黄色,碱性呈红色;硫代硫酸钠可被某些细菌还原为硫化氢,与硫酸亚铁中的铁盐生成黑色硫化铁;较高含量的氯化钠维持弧菌均衡的渗透压;琼脂是培养基的凝固剂。

副溶血性弧菌在3%氯化钠三糖铁琼脂上的特征
嗜盐性试验
•挑取纯培养的单个可疑菌落,分别接种0%、6%、8%和10%不同氯化钠浓度的胰胨水,36℃±1℃培养24 h,观察液体混浊情况。副溶血性弧菌在无氯化钠和10%氯化钠的胰胨水中不生长或微弱生长,在6%氯化钠和8%氯化钠的胰胨水中生长旺盛。

赖氨酸脱羧酶试验培养基
•具有氨基酸脱羧酶的细菌,能分解氨基酸使其脱羧生成胺(赖氨酸→尸胺)和二氧化碳,使培养基变碱,使指示剂显示出来。
•结果判读:阳性为试验管为绿色-蓝绿色,对照管变黄色; 阴性为试验管和对照管均变黄色,或均不变色。

3%氯化钠甘露醇发酵试验
•绝大多数细菌利用糖(醇)类作为碳源和能源,代谢产酸(如乳酸、醋酸、丙酸等),使酸碱指示剂变色来断定。
•(指示剂为溴甲酚紫)结果判读:阳性为变黄色; 阴性为紫色。

3%氯化钠甘露醇发酵试验
3%氯化钠葡萄糖磷酸盐胨水(VP试验)
•某些细菌能分解葡萄糖产生丙酮酸,并进一步将丙酮酸脱羧成为乙酰甲基甲醇,后面在碱性环境下被空气中的氧氧化成为二乙酰,进而与培养基中的精氨酸等所含的胍基结合,形成红色的化合物,即VP试验阳性。

我妻氏血琼脂(神奈川试验)
•酵母膏粉、蛋白胨提供氮源、维生素、生长因子;高含量氯化钠可以抑制非弧菌的细菌生长,不影响副溶血性弧菌生长;磷酸氢二钾为pH缓冲剂;甘露醇为可发酵的醇;结晶紫抑制革兰氏阳性菌,特别抑制革兰氏阳性杆菌和粪链球菌;兔血红细胞用于检测副溶血性弧菌是否具有特定溶血素;琼脂为凝固剂。
•阳性结果为菌落周围呈半透明环的β溶血。

副溶血性弧菌神奈川试验阳性
ONPG试验
•β-半乳糖苷酶试验是以有些细菌可产生β半乳糖苷酶,能分解邻硝基酚-β半乳糖苷(ONPG),生成黄色的邻硝基酚。

ONPG试验






